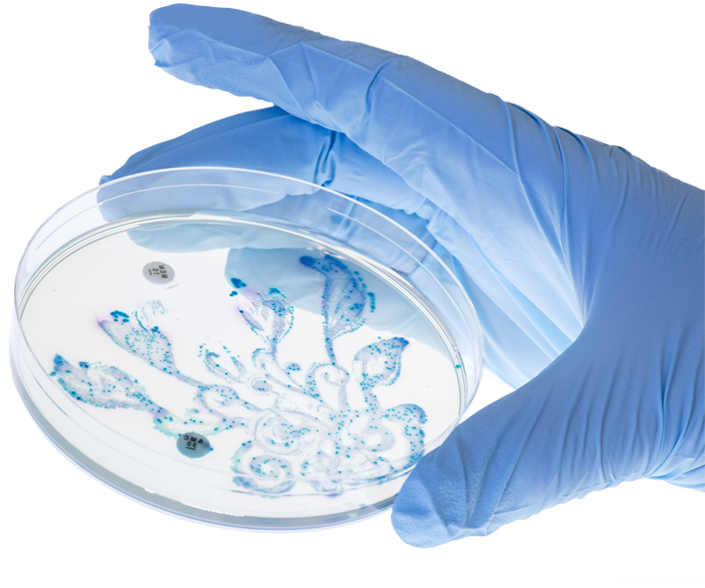

ASSESS
We use surveys, process reviews, and observations to conduct a preliminary assessment.

INTEGRION Technologies is set up to provide high ecological value to the environment by providing our clients with end-to-end scientifically proven, innovative solutions ranging from wastewater treatment to control agents. INTEGRION Technologies seeks to offer a more long-term preventative measure that is designed to help the greener generations of the future with better operations and cost-saving measures.
The concept of a cleaner future triggered the growth of AquaNex ®, a product which has been designed to reduce and eliminate chemical usage used to reduce wastes in order to create a better environment for the next generation.
Alongside the ability to degrade organic wastes, these innovative microbial and enzymatic solutions can also help eliminate bad odour and improve trade effluent to a standard good enough for discharge into public sewers.
Often meeting and exceeding the trade effluent standards set by the local authorities, these wastewater treatment solutions are a real game-changer for business to increase their presence in the global fight against damage to the environment.
We use surveys, process reviews, and observations to conduct a preliminary assessment.
We identify technology and processes that fits you to take your service team to the next level.
We provide required training and jointly oversee the implementation process from start to finish.
We monitor and analyse performance and efficacy of the system and fine-tuning of the solutions as part of the control program.